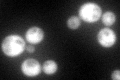
YDR454C
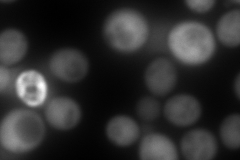
YDR454C
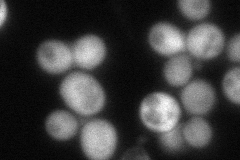
YDR454C
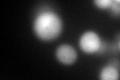
YDR454C
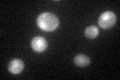
YDR454C

View description
Guanylate kinase, converts GMP to GDP; required for growth and mannose outer chain elongation of cell wall N-linked glycoproteins
Localization:
Intensity:
Fold change:
Significance:
-
C’ GFP library in SD
cytosol121.83 -
N' NOP1pr-GFP in SD

cytosol372.949 -
N' TEF2pr-mCherry in SD
cytosol528.658 -
N' NATIVEpr-GFP in SD
cytosol99.6007 -
N' TEF2pr-VC and Cyto-VN in SD

#N/A0 -
C’ GFP library in SD+DTT
cytosol106.410.87No -
C’ GFP library in SD+H2O2

cytosol95.50.78No -
C’ GFP library in Starvation Media
cytosol94.30.77No -
C’ GFP library on the background of Pup2-DaMP

cytosol -
C’ GFP library on the background of CCT mutant

cytosol101.4940.833036No
